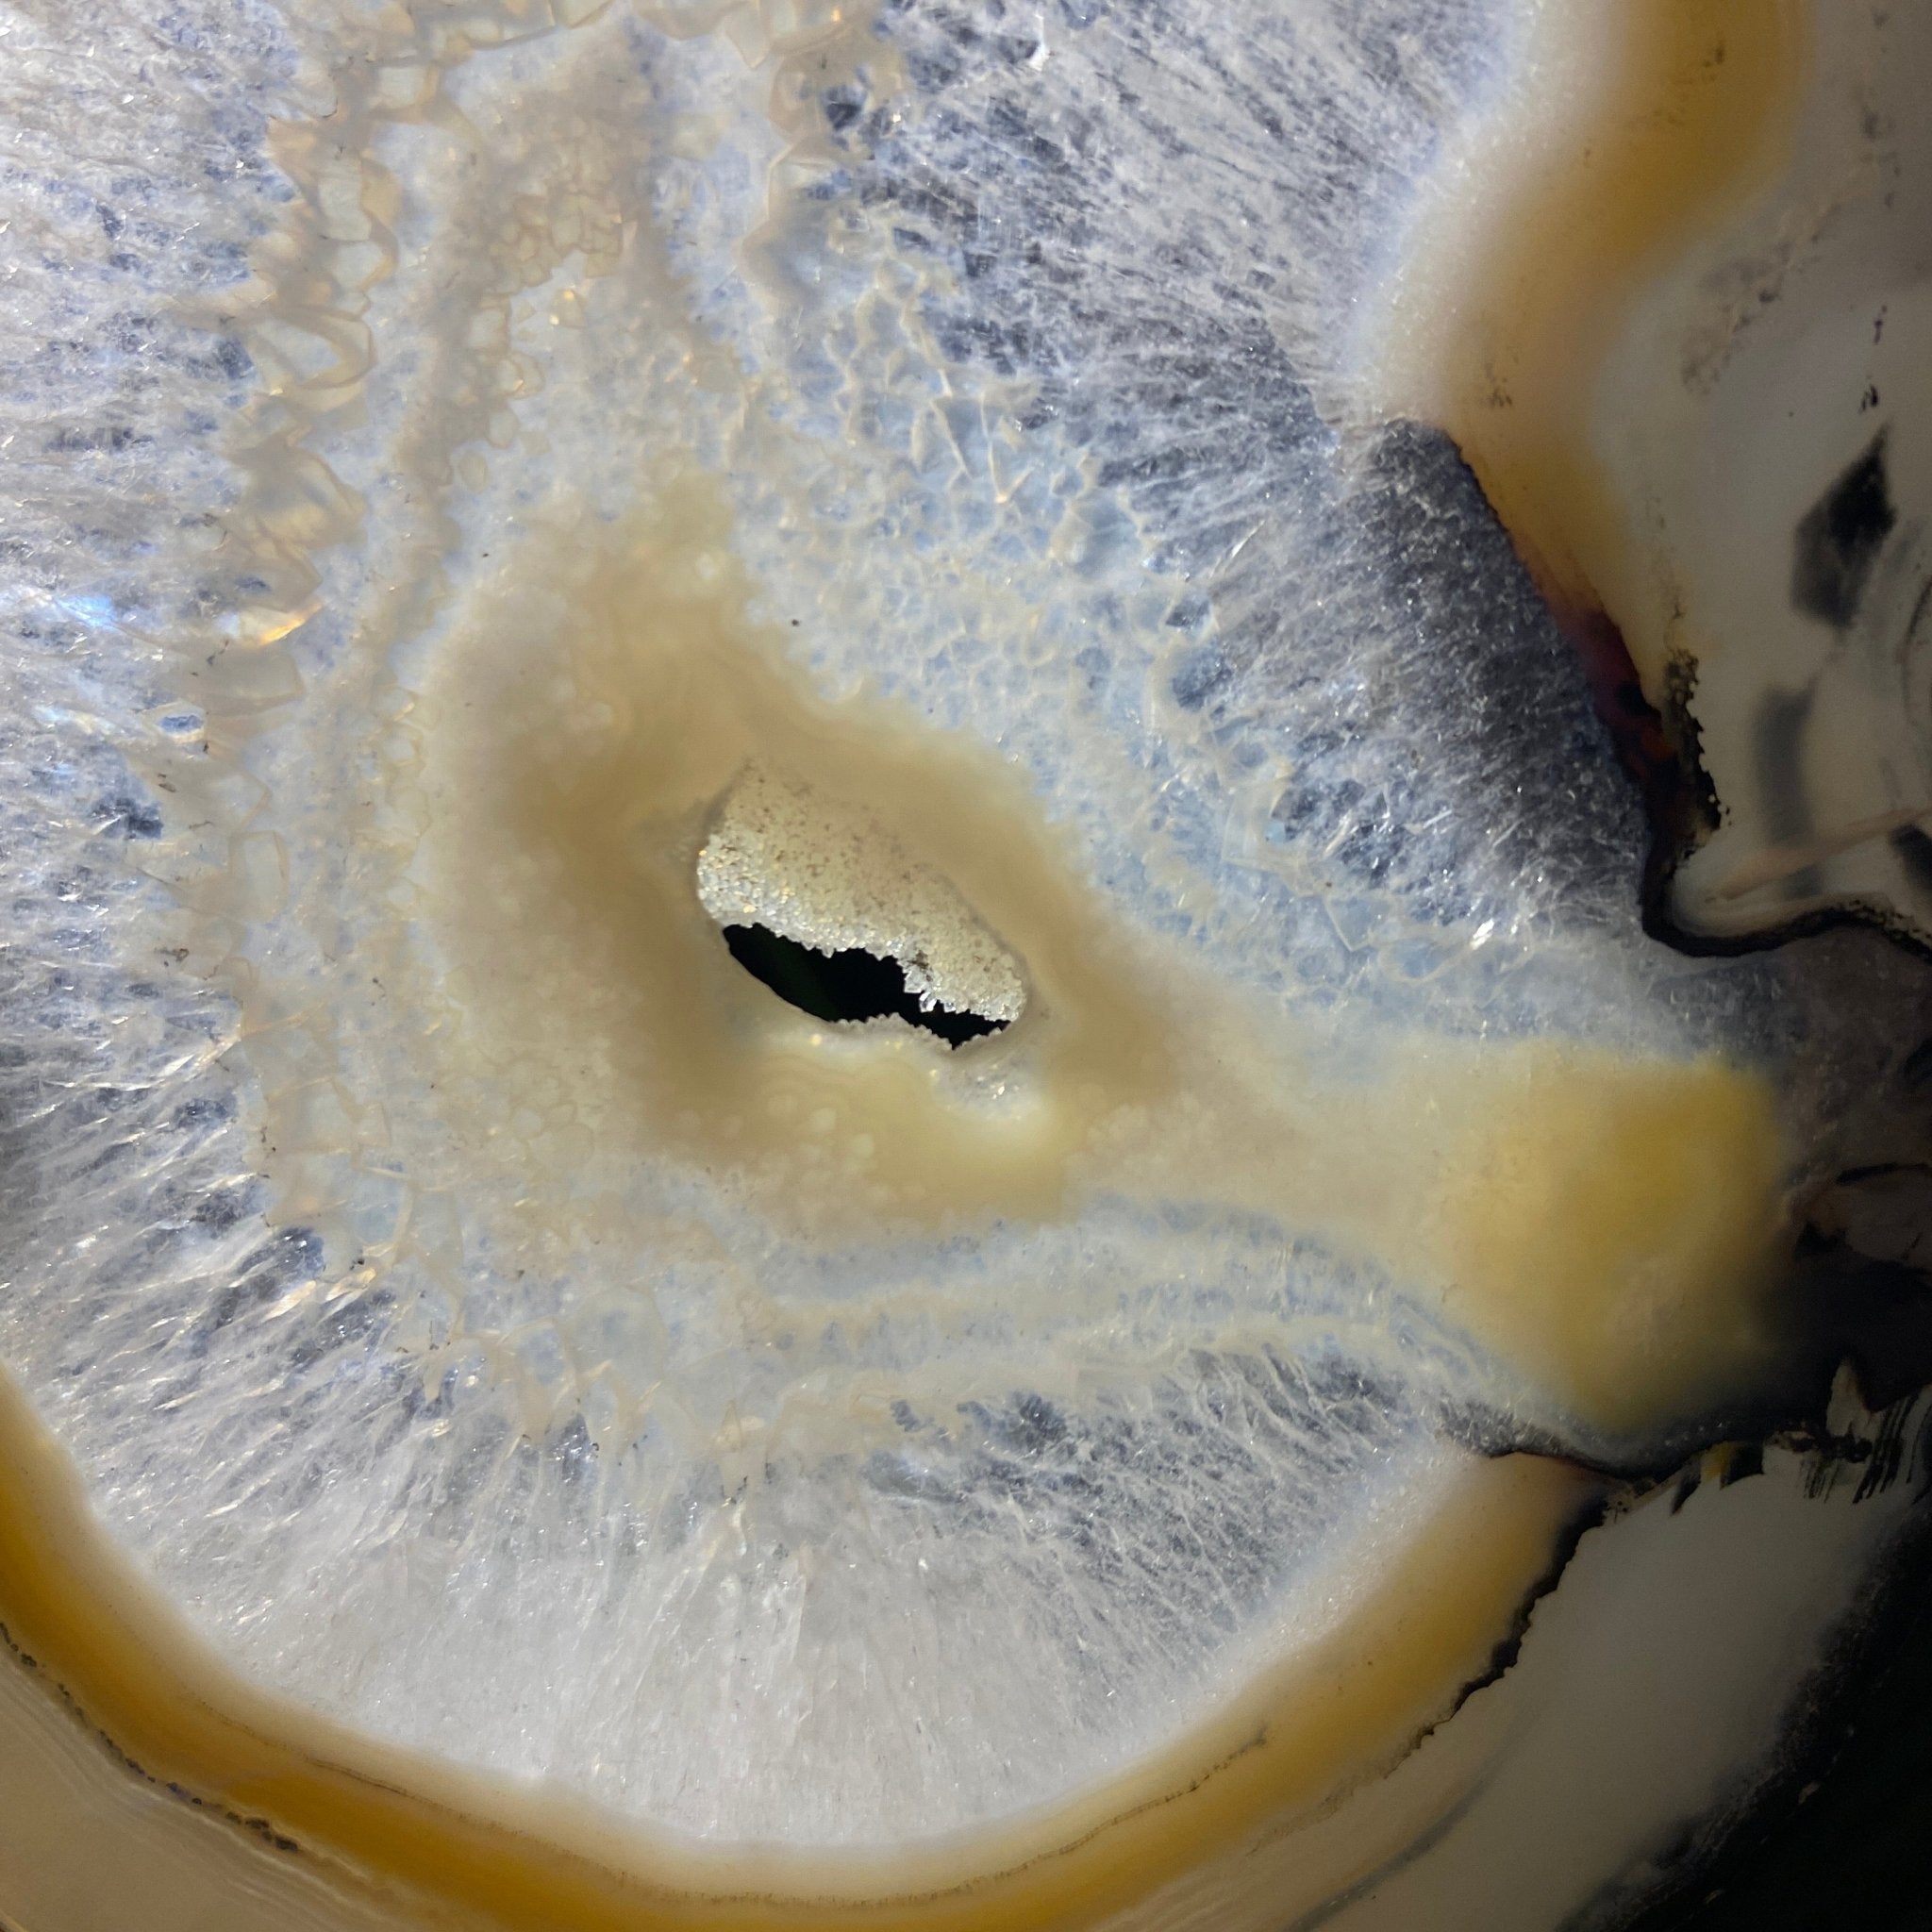

Agate Butterfly Wings
Natural & Died Brazilian Agate Slices beautifully displayed as Butterfly Wings on a black metal stands. These are delicate and elegant pieces that will accent any décor and make for great gifts to a loved one. They are translucent and will look amazing with light behind it or placed by a window.
After millions of years in the making the beauty of Agate stone is revealed after a delicate cutting process. Two back to back Agate slices are required to create these "butterfly wings". Make them yours today!
Agate Butterfly Wings
AGATE BUTTERFLY WINGS
Natural and Dyed Brazilian Agate Slices displayed as Butterfly Wings on a black metal stand. These are delicate and elegant pieces that will accent any décor and make for great gifts to a loved one. They are translucent and will look amazing with any light behind or placed by a window.
Only after hours of cutting an agate stone open with a diamond saw is when it reveals its beauty of millions of years in the making. Larger Agate slices are harder to find as a pair because it requires cutting 2 similar slices of agate from the same stone without breaking it to make "butterfly wings". Make them yours today!
These are natural gemstones sold as is and as you see them in their images and videos. The exact piece you see and purchase is the piece you will receive. They may contain natural imperfections and/or imperfections, repairs and broken edges from the extraction, slicing, polishing and mounting processes.
AGATE: Protection - Strength - Courage
The many shades of Agate can offer a talisman for courage through times of sunshine and shadow. It offers protection and grounding energy, enhancing feelings of security. If you are in a season of worry or overthinking, Agate can invite healing energy to your inner world.
Agate is formed in the cavities of ancient volcanic rocks. After the rock cools, microcrystal fibers collect as water pools or passes through. The layers build up over time, with different colors reflecting differences in the water’s composition. The result is a colorful reminder of the power of strength built with time.